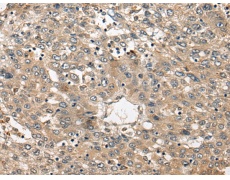
一抗

|
Background: |
The product of this gene transfers fucose to N-acetyllactosamine polysaccharides to generate fucosylated carbohydrate structures. It catalyzes the synthesis of the non-sialylated antigen, Lewis x (CD15). |
|
Applications: |
ELISA, IHC |
|
Name of antibody: |
FUT4 |
|
Immunogen: |
Synthetic peptide of human FUT4 |
|
Full name: |
fucosyltransferase 4 |
|
Synonyms: |
LeX; CD15; ELFT; FCT3A; FUTIV; SSEA-1; FUC-TIV |
|
SwissProt: |
P22083 |
|
ELISA Recommended dilution: |
5000-10000 |
|
IHC positive control: |
Human liver cancer and human colorectal cancer |
|
IHC Recommend dilution: |
30-150 |


 購(gòu)物車
購(gòu)物車 幫助
幫助
 021-54845833/15800441009
021-54845833/15800441009